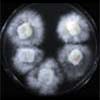

Please send cultures together with information about them. Complete the Culture Submission Form and send by email attachment to curator@uamh.ca. Also send a printed copy of the Culture Submission Form with the cultures.
Please provide as much of the following information as available as this guides us in entering correct information into the database and in choosing optimum methods for handling your organism(s).
- Species name, species authority and species original publication information.
- If you are depositing a culture representing a new species, please provide the authority, journal of publication and approximate publication date. A copy of the accepted publication or relevant pages describing the new fungus would be helpful to guide our handling of the organism.
- Isolation data including host or substrate, location collected including geographical coordinates if available, name of isolator (and collector if different).
- State any special media or growth conditions required, including recommended temperature.
- The number assigned to the isolate by the collector and / or isolator.
- Provide the accession number assigned to this isolate by other collections if deposited elsewhere (e.g. DAOM, ATCC, CBS, IMI, etc.)
- Provide GenBank accession numbers for any deposited sequences.
- If the isolate is cited in a scientific publication, please provide the complete reference (authors, title, journal, date) and copy of the publication, if possible.
- Any other pertinent information including non-copyrighted images is appreciated.
Ensure that your work is scientifically reproducible by sending a culture for deposit.

Why deposit?
- You are sequencing
- You are describing a new species
- An isolate is described in a case report
- The fungus occurs on an unusual habitat or one that has not been extensively studied
- Your isolate produces novel compounds or has unusual characteristics
- The fungus is new to Canada or adds to information on the Canadian mycobiota

Storage of cryopreserved cultures.
